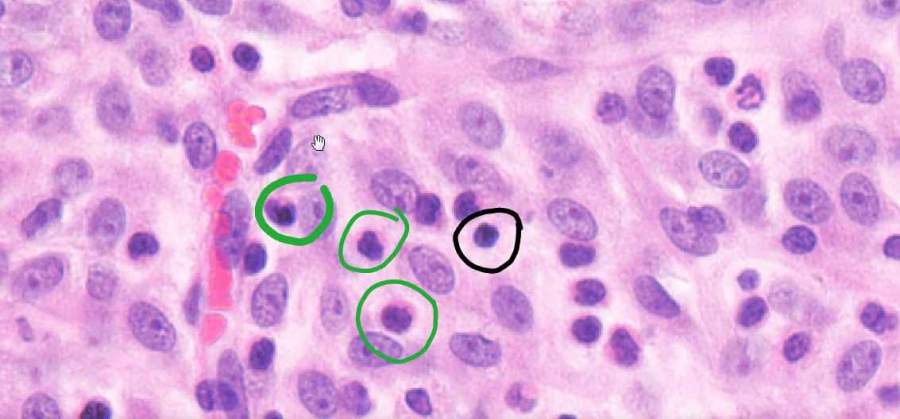
补硒后脸干口干（补硒后便秘是什么原因）-硒宝网

补硒后脸干口干(补硒后便秘是什么原因)
补硒后的调理反应(收藏版)导语1.人体胃细胞 7 天更新一次; 2.皮肤细胞 28 天左右更新一次; 3.肝脏细胞 180 天更换一次; 4.红血球细胞 120 天更新一次; 5.在一年左右的时间,身体 98%的细胞都会被重新更新一次,而骨细胞更新需 要 7 年,所以不管你有三高、癌症、肠胃、亚健康等任何问题,请给身体一点时 间,用科学的补硒方法,改善体质。1、什么是调整反应 ? 调整反应,中医称之为“瞑眩反应”,在保健及调理过程中,必然会有各种各样 的调整反应?!妒榫烦啤耙┎活ㄑ?,厥疾勿瘳”,其意为服药后 ,若人体没有明 显的反应 ,则疾病难以被治愈。 我们体会 ,虽服药愈病并非均有明显反应 ,但若药后 有较明显反应者常收效较好。2、补硒后有调整反应是好事吗? 补硒后有调整反应是件好事, 硒对于病态细胞具有靶向识别的能力, 能够打乱人 体病态平衡, 重新调整为健康平衡, 是人体免疫系统被激活了, 人体脏腑的功能 恢复了,器官工作强度增大了,巨噬细胞吞噬病毒的能力加强了, T 细胞, B细 胞的识别能力增强了,白细胞的攻击能力,战斗能力增强了。补硒后的调理反应有哪些口干、舌噪、尿频、放屁多、排便通畅这是人原来身体酸性过多, 补硒时排出细胞内多年的水分, 油腻, 废物等物质所 表现的特征,这是排酸的表现,需要大量喝水。
耳鸣、心慌、胸闷 这是鼻炎、咽喉炎、扁桃体炎、心脏病、高血压、腹痛的一种表现,这是活血化 瘀的一种表现。贪睡、睡不醒 这是体内毒素太多,血呈酸性,肝脏有病的一种表现,肝的排毒和修复,是要在 睡眠中完成,这是修复的必然反映。眼屎多、眼红肿、眼疼这是肝气疏通上后, 从眼中排出会使眼肉微循环, 微血管, 微弹性恢复疏通的一 种表现,瘀堵在眼内的病毒向外排出的反映。眩晕 这是贫血,气虚,高血压,高血脂,高血粘度,痰阻,肝胆气不足人的表现,这 是血流加快的一种表现, 是由于原来很慢的血流量加快后, 血管收缩能力跟不上, 不同步的表现。口腔溃疡 这是人体舌下腺(胃),腮腺(脾),腭下腺(肾)的热,火,毒向外排泄时, 大量的在口腔内淤积形成的,多漱口能缓解。为什么服用硒一段时间后皮肤痒糖尿病,血糖不稳定,肾病,肝胆类疾病,寄生虫病,肿瘤,内分泌紊乱的必然 反映,硒有“人体清道夫” 的美誉,是硒清除大量废物, 病毒从皮肤排泄的表现。1、白细胞吞噬能力增强,皮部组织出现奇痒,病变部位气血流通了。2、肾功能不好,气滞血淤的人,会反映皮肤奇痒无比,是皮肤无法应对大量毒 素的排出。3、皮肤出现小红肿,小红块,风疹块,呕吐,是胆囊炎,胆汁返流性疾病的一 种表现,人体血液、体液内的废物在皮肤弱酸环境中的反映。

皮肤承受不了调节, 产生各种新的瘀堵,这是暂时的。4、皮肤溃烂,流水,脱皮,局部肿大,是皮肤微循环瘀堵,流通不畅的一种表 现,是原来瘀堵和病变的局部被打通了。5、头皮痒、头屑多,这是典型的肾阳虚反映,原来瘀堵在头皮的毛囊内脂肪和 废物被大量排出后产生的适应感觉。为什么服用硒一段时间后会产生各种疼痛各种疼痛,是由于补硒后,血流量增强, 硬化萎缩,瘀堵的微血管开始恢复弹性, 后面推,前面堵,会牵拉周围的组织,就会反映疼痛,有的人反应强烈,有的人 反应弱。1、局部肌肉酸痛,胀痛,刺痛,这是肌肉微循环严重堵塞。2、关于胯骨,颈椎,腰椎,酸痛,刺痛,痛无定处,这是关节炎,风湿性,类风湿性、股骨头炎的一种表现,越痛说明越严重。3、意想不到的局部出现疼痛,说明这个部位有淤积。4、全身无力,全身酸痛,或者发烧,这是月风病,风湿类疾病,心脏病,痛风 病的反应。 巨噬细胞吞噬病毒的能力增强了, 机体应变能力差, 暂时不能适合新 的平衡。5、头痛,这是脑血管萎缩,微循环瘀堵,脑肿瘤,脑神经功能不稳定的反映, 微血管恢复弹性时,改变了周围组织的形态。6、小腹疼痛,胀痛,极不舒服,是原来有盆腔炎,子宫位置不正,子宫肌瘤, 子宫内膜异位,宫颈炎,阴道炎等的反映。
7、手足疼痛,这是末梢神经,微循环恢复的反映。8、抽筋,腹部等部位酸痛加腹部疼痛:这是糖尿病或者胰腺炎等病人的反映。9、腰疼,腰胀,腰酸:肾不好,肾炎,肾结石,膀胱结石,输尿管结石,输卵 管,子宫肌瘤等疾病的反应, 是活血化瘀,结石松动, 血管恢复弹性的一种表现。10、胃痛并发有呕吐、 胃胀、排气多,这是胃病, 胆汁返流性胃炎, 萎缩性胃炎, 浅表性胃炎,胃窦炎等的反映,这是一种修复,排毒,提高胃功能的一种表现。11、胆汁区疼痛:补硒调理后疼痛者,这是疏通的表现,原来瘀堵的血管,肝组 织被疏通和分解,逐渐恢复功能的一种表现。12、淋巴痛,咽喉红肿,口腔内痒,咳嗽,这是淋巴结, 咽喉,等有疾病或瘀堵, 病毒结合物,废物体,淤血点,粘膜内废物开始松动或分解,疏通。当体内元气得到补充, 就会对病邪进行消灭和向体外清除。 所以在补硒时有反应 是好事情,当人体阳气充足了,就会不断地输向全身经络、脏腑,它会自动找出 哪里需要修复。 就像我们修房子, 这里要换块砖那里要换块瓦, 身体曾经有的问 题在改善的过程中都会再暴露出来, 时?;共恢挂淮危?必须反复的改善直到体内 完全达到平衡为止。补硒后的调理反应(下)青春痘加剧 这是补硒后皮下脂肪大量排泄的一种现象。
咳嗽、痰多、伴有气喘、头晕这是支气管、气管、咽喉、肺内的死痰、淤血,向外排泄时刺激组织的一种本能 反映。流血1、流鼻血、流鼻水、流黄鼻水:这是血红素,不是鼻血,原来血管硬化,萎缩, 或者原来流过血的人以及脾、肝功能不好的,补硒后重新恢复功能的表现。2、月经不停、出血时间长:严重气滞血瘀、子宫内膜增厚、子宫内膜异位、子 宫肌瘤、宫颈糜烂。3、便血:这是肠息肉、肠炎、痔疮病人的反映,活血化瘀过程中,将原组织在 各部位的淤血分解后排泄出的反映。4、尿血:这是肾结石、输尿管结石、膀胱结石人的反映,这是在疏通过程中结 石松动,排泄中碰伤了血管内膜渗血的反映。尿臭、尿多、尿酸高、尿的泡沫多、尿白浊、尿绿这是高血糖、糖尿病、肾病、胰腺炎、膀胱炎体质的人泌尿系统有炎症的特有表 现,这是一种排毒、恢复功能的反映。尿白浊是肾病、膀胱有病,这是消炎、消 毒、恢复功能的反映,尿绿是胆有病,这是胆汁大量排出时,人体无法分解或者 与各种食物结合,溶化的一种表现,也是一种恢复的表现。腹腹泻这是典型的肝胆、胆囊炎、肠炎、体质差的人的表现,也是排毒现象。 气急、气短、心跳加快1、贫血:血流量增大,流动的速度快了,各种器官无法适应和调整。
2、心功能不好的人:心脏的博血和回流血来不及协调。 手、脚、身体浮肿 这是糖尿病、肾病、膀胱病、心脏病、胰腺病人的一种表现。这是补硒后排泄加 快,自身器官组织、修复、消化能力跟不上的反映 血脂、血糖、血压升高许多人在补硒调理时,都会发生此类状况,这都是一种调整修复反映,同时,都 是一种假性症状, 不管怎样反映, 自我感觉是良好的, 不象过去的症状那么让人 害怕,即根源已经好了,但还有一些调节现象没有结束。1、血脂升高:高血脂、高血粘度的人的一种表现,细胞内的多余血脂被大量分 解出,排到血液内,人体自身分解血脂的能力跟不上调整反应。2、血糖升高:这是糖尿病、血糖高、胰腺有病的人特有的,也是一种假象反映, 细胞多余的糖会被大量排出,细胞的活力大大增强,人体的自我感觉越来越好, 如果细胞内堆积的糖分不排出, 必然会产生各种并发症, 细胞死了, 器官组织必 然会衰亡。3、血压升高:这是高血压,血管萎缩,硬化特有的反映,血液循环增大了,血 管的韧性未恢复,还不能适应环境的变化。饭量减少和增强这都是胃功能不好的人的反映1、饭量减少:是新陈代谢加快了,胃动力未解决好。2、饭量增加了:是胃功能恢复了,新陈代谢也加快了的反映。
胖了和瘦了内分泌在补硒调整过程中的反映, 尤其甲亢都会胖。 瘦了, 是体内细胞活力加强 了,细胞内的脂毒,脂肪大量排出形成的。反应太大,害怕 这是补硒后的好转反应, 吃药是没有反应的, 它是在默默地破坏, 而补硒调整是 在帮你找出病况,在调整,疏通,恢复和提高身体各个器官的功能和作用。特别说明由于个体差异原因, 补硒后出现反应的只是部分人, 相当一部分人服用后没有明 显反应,而是直接转为轻松、健康的感觉。疾病越杂、健康状况越差的人,补硒后出现调整反应而采取相应措施仍不减轻时, 应暂时减少服用量,待反应减轻或消失后再恢复原来的用量。补硒后的调整反应通常为 3–5 天,最短的半天,长的可达十天半月,甚至一个 月之久, 这是因为各人的体质、 疾病程度、 病程长短等生活习惯的不同而有所差 异。通常是健康状况越差的人反应的可能性越高; 有的人身体有多种病症, 调整 反应不会一下子全部发生, 而是逐渐在身体的不同部位陆续反应出来; 平时身体 健康、无不适情况的人使用富硒产品后,一般不出现调整反应。
继续阅读
- 暂无推荐
